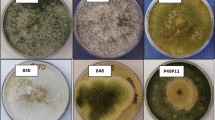

Abstract
Thermoascus aurantiacus is able to secrete most of the hemicellulolytic and cellulolytic enzymes. To establish the xylanase inducers of T. aurantiacus, the mycelia were first grown on glucose up until the end of the exponential growth phase, followed by washing and re-suspension in a basal medium without a carbon source. Pre-weighed amounts of xylose (final concentration of 3.5 mg/ml), xylobiose (7 mg/ml) and hydrolyzed xylan from sugarcane bagasse (HXSB) which contained xylose, xylobiose and xylotriose (6.8 mg/ml) were evaluated as inducers of xylanase. It was observed that xylose did not suppress enzyme induction of T. aurantiacus when used in low concentrations, regardless of whether it was inoculated with xylobiose. Xylobiose promoted fast enzyme production stopping after 10 h, even at a low consumption rate of the carbon source; therefore xylobiose appears to be the natural inducer of xylanase. In HXSB only a negligible xylanase activity was determined. Xylose present in HXSB was consumed within the first 10 h while xylobiose was partially hydrolyzed at a slow rate. The profile of α-arabinofuranosidase induction was very similar in media induced with xylobiose or HXSB, but induction with xylose showed some positive effects as well. The production profile for the xylanase was accompanied by low levels of cellulolytic activity. In comparison, growth in HXSB resulted in different profiles of both xylanase and cellulase production, excluding the possibility of xylanase acting as endoglucanases.
Similar content being viewed by others
Avoid common mistakes on your manuscript.
Introduction
The use of thermophilic enzymes in biotechnological processes began three decades ago (Sonnleitner and Fiechter 1983). Some of these enzymes are commercially available such as hemicellulases (Enzymatic Deinking Technology, LCC). Besides high thermostability, they have a longer useful life, of several hours at 70°C or a number of days at 60°C (Alam et al. 1994). Cellulases, xylanases and hemicellulose-debranching enzymes (Parry et al. 2002; Gomes et al. 2000; Roche et al. 1994; Khandke et al. 1989; Kalogeris et al. 2001, 1998; Maslen et al. 2007; Vardakou et al. 2003) were intensively studied. These later enzymes, also known as accessory enzymes, have many applications such as in the modification of hemicellulose, which can be used for hydrogel production (Gabrielii et al. 2000), or for addition with cellulosic pulp to improve the quality of paper (Lima et al. 2003).
Cellulases and hemicellulases are of industrial interest in supplementation of animal feed and for the manufacturing of food, drinks and bread (Maat et al. 1992; Bedford and Classen 1992). There are also further potential applications of these enzymes in the textile industry, for the bleaching of cellulose pulp and for second generation ethanol production (Kuhad and Singh 1993). In these applications the price of the enzymes must be low to make their use economical. For this reason, research has turned to study inducers and low cost materials as substrates for specific enzyme production (Leite et al. 2008). Components of lignocellulosic materials have emerged as a source of low cost substrates for growing several fungi with respect to enzyme production (Dobrev et al. 2007; Couri et al. 2000; Kang et al. 2004; Kovács et al. 2009; Juhász et al. 2005).
Thermoascus aurantiacus is a prominent microorganism for thermostable enzyme production (Leite et al. 2008; Chang and Holtzapple 2000; Mansfield et al. 1999). Extracellular xylanase synthesis by T. aurantiacus is largely inducible. Compared to growth on wood xylans, fungi produce enzymes in larger amounts than on other carbon sources (Milagres et al. 2004). Since xylan is a large polymer, which cannot penetrate the mycelia, it must be anticipated that xylanase is induced by fragments of xylan. The studies on regulation of xylanases in fungi are complicated by the fact that in most species production of xylanases is accompanied by production of cellulolytic enzymes independent of the carbon source used as the growth support (Biely et al. 1980). Numerous xylanases and cellulases of fungi, including T. aurantiacus have been shown to possess certain substrate cross-specificity once xylanases have cellulose binding domains with little affinity to recognize xylan or cellulose (Da Silva et al. 2005). A description of catalytic properties of T. aurantiacus enzymes, their stability and xylanase families were recently revised (Brienzo et al. 2009a).
Endoglucanase from T. aurantiacus is more stable than endoglucanases produced by other fungi (Parry et al. 2002). Significant reduction in the cost of cellulases production by means of cheaper substrates and increased volumetric productivity will be important for their applications. Lignocellulosic substrates are used for production of cellulolytic enzymes under submerged cultivation or solid-state fermentation. However, fungal growth on insoluble substrates has been connected with a delayed enzyme production that lowers productivity (Kang et al. 2004; Juhász et al. 2005; Gomes et al. 2000). The search for compounds related to the structure of lignocellulosic materials responsible for cellulase and hemicellulase induction remains a challenge. In the present study xylan hydrolyzate containing small-molecular-weight carbohydrates; xylose, xylobiose and hydrolyzed xylan from sugarcane bagasse (HXSB); were used to grow T. aurantiacus in an attempt to find potential inducers of cellulases and hemicellulases.
Materials and methods
Microorganism
A strain of T. aurantiacus ATCC 204492, an isolate of eucalyptus chips (Auer et al. 1988), was grown on potato dextrose agar (PDA) at 45°C for 4–5 days and stored at 4°C. Before experiments the cultures were transferred onto the same fresh medium in the incubator at the same condition.
Cultivation
Mycelial biomass was grown on 25 ml of basal medium in 125 ml Erlenmeyer flasks. The basal medium was comprised of Vogel’s salt (Vogel 1956), which was supplied with 1% of glucose for growth. The medium containing basal medium and glucose was inoculated with 4–5 day old spores at a concentration of 1 × 104 spores/ml. The cultivation was carried out at static conditions for 72 h at 45°C.
Induction experiments
Mycelia grown in the basal medium supplied by glucose were washed with 100 ml of cold distilled water and suspended on 25 ml of basal medium (Vogel’s salt medium without glucose) and supplied with 20 mM of xylose (final concentration of 3.5 mg/ml), xylobiose (7 mg/ml) or hydrolyzed xylan from sugarcane bagasse (HXSB) (6.8 mg/ml). The mixtures were incubated in a rotary shaker at 45°C and 120 rpm. After 6, 10, 24 and 30 h samples were taken, centrifuged at 10,000xg for 15 min and the supernatant was then used to determine enzyme activity and substrate consumption. A control assay was run in parallel at the same conditions without a carbon source.
Growth experiments
Thermoascus aurantiacus was cultivated on xylose, cellobiose, sugarcane bagasse xylan (XSB), birchwood xylan, oat spelt xylan, carboxymethylcellulose (CMC), avicel and hydrolyzed xylan from sugarcane bagasse (HXSB). The media (50 ml) was prepared with Vogel’s salts, at a pH of 5.8 containing 1% of the applicable carbon source. The 250 ml Erlenmeyer flasks were autoclaved for 15 min at 121°C, followed by inoculation with 2 × 105 spores/ml. The flasks were agitated for 96 h at 120 rpm and 45°C. Samples were taken every 12 h and centrifuged at 10,000xg for 15 min followed by determination of enzymatic activities. A control assay was run in parallel at the same conditions without the carbon source.
Enzymes assays
Xylanase activity was assayed on birchwood xylan by liberation of reducing saccharides (Miller 1959). One unit (U) of xylanase is defined as the amount of enzyme required to liberate 1 μmol of xylose from xylan during 1 min at the standard conditions. Endoglucanase assay was performed at the same conditions as xylanase using a solution of carboxymethylcellulose (0.44%) and glucose as a standard (Tanaka et al. 1981). β-xylosidase was performed with p-nitrophenyl-β-xyloside (Tan et al. 1987). The assays of β-glucosidase and α-arabinofuranosidase were performed at the same conditions using p-nitrophenyl-β-glucoside and p-nitrophenyl-arabinofuranoside as substrates, respectively. The enzyme activity was expressed as μmol of p-nitrophenol formed per milliliter per minute of enzyme solution (U/ml).
Production of HXSB
The xylan of sugarcane bagasse was extracted with hydrogen peroxide in alkaline media according to optimized condition in previous work (Brienzo et al. 2009a, b). The xylan (2%, w/v) was hydrolyzed by an enzymatic extract of T. aurantiacus (60 UI/g xylan), at a pH 5, a temperature of 50°C and with an agitation of 120 rpm. After reaching the reaction time of 96 h, the pH of the medium was adjusted to 6.5 and the tubes were heated in boiling water for 5 min. Upon completion, the samples were centrifuged at 10,000xg for 15 min and the reaction products were further analyzed by HPLC to determine the degree of polymerization (DP) of the xylooligosaccharides.
Determination of substrate consumption
Xylose, xylooligosaccharides (XOs) and cellobiose were monitored by liquid chromatography with a refractive index detector and a BIO-RAD Aminex HPX-42A column (300 × 7.8 mm). Before injection, samples were filtered through a Sep Pak C18 filter. Aliquots of filtered sample (20 μl) were injected onto the HPLC system. The components of the medium such as xylooligosaccharides, xylose and cellobiose were eluted using distilled/deionized water as the mobile phase. The concentration of xylooligosaccharides were quantified using standard xylose (Sigma) and xylobiose (X2), xylotriose (X3), xylotetraose (X4) and xylopentaose (X5) (Megazyme-Irlanda).
Results and discussion
Hemicellulases and cellulases inducers
Cellulases and hemicellulases are produced at different levels in the same induction medium by T. aurantiacus (Fig. 1). It was hypothesized in this work that compounds related to the hemicellulose structure can be responsible for hemicellulase and cellulase production. To check whether xylan derivatives act as inductors, the washed-mycelia were incubated in a basal medium supplied with a low concentration of xylose, xylobiose or hydrolyzed xylan from sugarcane bagasse (HXSB). The control test was conducted in the absence of inducers. No enzymatic activity and no growth of mycelia growth was detected in the control, confirming that the enzymatic activities in the cultures were really induced by the saccharides.
Time course of enzyme production by T. aurantiacus in washed glucose-grown mycelia transferred to basal medium supplied with low concentrations: xylose (open diamond), xylobiose (multiplication symbol) and hydrolyzed xylan from sugarcane bagasse (HXSB). Enzyme activities determined were: xylanase (filled square), arabinofuranosidase (open triangle), endoglucanase (closed circle), β-glucosidase (open circle) and β-xylanase (closed triangle). Standard deviation of triplicate assays less than 5%
Enzymes activities related to cellulose and hemicellulose degradation were monitored at various time intervals (Fig. 1). Xylanase was detected in all media, but showed a higher activity in media containing xylose and xylobiose compared to media containing hydrolyzed xylan from sugarcane bagasse (HXSB), which is composed of a mixture of xylose, xylobiose and xylooligosaccharides. The production of xylanase peaked at 24 h in media containing xylose, even after the exhaustion of xylose, which occured after 10 h of incubation (Fig. 1a). Although reports concerning the inducing effect of xylose have been somewhat controversial, the common notion is that xylose at low concentrations acts as an inducer and at higher concentrations as a repressing carbon source (Aro et al. 2005). It was demonstrated that genes encoded for the xylanolytic enzymes in fungal species are induced by xylose (Purkarthofer and Steiner 1995). With respect to T. aurantiacus, Gomes et al. (1994) observed that readily metabolized substrates were ineffective as inducers of xylanase. Furthermore in A. niger, xylose induced expression of several other genes in addition to those encoding xylanases, including genes related to the side chain cleaving enzymes, α-glucuronidase, acetylxylan esterase and feruloyl esterase (faeA) (Aro et al. 2005). These enzymes could be induced by the chemical or mechanical release of specific oligosaccharides from xylan, or by some other unknown sensing mechanism (Chavez and Bull 2006).
Induction of xylanase with xylobiose was initiated in a short period of time and increased up to the first 10 h, even at low consumption of the carbon source. After this time the endoxylanase activity remained constant suggesting that low amounts of xylobiose can induce endoxylanase activity (Fig. 1b). β-xylosidase can both cleave xylobiose into xylose and perform the reverse reaction through a transglycosylation step and make the real inducer, which would lead to enzyme production (Gomes et al. 2000). The β-xylosidase of T. aurantiacus has transxylosidase activity, as xylotriose and xylotetraose were produced in low content from xylobiose (Matsuo et al. 1998).
Only negligible xylanase activity was determined in the media supplied with HXSB, showing a peak at 6 h of cultivation. Medium supplemented with HXSB produced mainly endoglucanase and β-glucosidase. The xylose content of HXSB was totally consumed after 18 h, while xylobiose was partially consumed at a slower rate than in the media with only this carbon source. At the end of the experiment xylobiose was the only remaining sugar, and only 24% had been consumed (Fig. 1c). Comparatively, in the assay with xylobiose as the only carbon source its consumption was 62%. A simultaneous consumption of xylose and xylobiose was observed in the HXSB media. β-xylosidase produced in HXSB can cleave xylobiose into xylose, which could cause repression depending on the balance of hydrolysis and uptake, however this effect was not apparent.
The profile of endoglucanase activity was coincident with the xylanase in xylose and xylobiose media; however the enzymes produced were four times lower. On the other hand, the levels of endoglucanase and β-glucosidase were the same as those produced in xylobiose, suggesting a constitutive expression. Endoglucanase activity has been detected in cultures of T. aurantiacus where HXSB was supplied, suggesting that an induction mechanism is involved in the presence of oligosaccharides. It is possible that a compound derived from carbohydrates released from sugarcane bagasse has provoked an inductive intracellular signal.
Effect of carbon source on enzyme production
Thermoascus aurantiacus was grown on media containing various carbon sources. After 4 days of growth the activities of cellulases and hemicellulases were determined (Table 1). The highest level of xylanase (70 U/ml) was obtained in the medium containing xylan from sugarcane bagasse (XSB). In other xylan sources, the activity was smaller by about five orders of magnitude. Low basal activity of xylanase was detected on carboxymethylcellulose and avicel medium. The ability of xylanase production was observed in other microorganisms growing in the cellulosic substrate. Carboxymethyl cellulose or xylan can induce xylanases production by P. funiculosum (Rao et al. 1988). Raw material can also induce this microorganism. High production was obtained when sugar cane bagasse, rice straw and wheat straw were used (Fadel and Fouda 1993).
The highest xylanase activity which was detected in medium containing sugarcane bagasse xylan can be attributed to its high solubility. The chemical composition of xylan from bagasse may have influenced the xylanase production. The content of xylose (76%), lignin (5.9%), arabinose (4.6%), glucose (4.9%) and uronic acid (5.7%) was quite different from oat spelt xylan and birchwood xylan (Brienzo et al. 2009b).
The α-arabinofuranosidase activity was detected in growth media provided by hemicellulose resources, revealing that the production of this enzyme is coupled with the expression of hemicellulolytic system. The α-arabinofuranosidase activity was performed on artificial substrate 4-NPh- α-L-Araf and some α-L-arabinofuranosidases, e.g. those of family 43, show a very low specific activity on this substrate.
The total of xylanase production was much lower in the presence of soluble carbohydrates (xylose, cellobiose and HXSB) than in the medium with xylan. Soluble carbohydrates are easily consumed and do not require elevated enzyme production at growth condition. The growth of Thermoascus aurantiacus in xylose produced mainly xylanase and endoglucanase, and lower activities of β-glucosidase and α-arabinofuranosidase (Fig. 2a). The peak of endoxylanase production occurred at 46 h, whilst the consumption of xylose starts diminishing.
Time course of enzyme production by T. aurantiacus growth in 1% of xylose, cellobiose, hydrolyzed xylan from sugarcane bagasse (HXSB). The substrate consumption was monitories: xylobiose (multiplication symbol), xylose (open triangle) and xylooligosaccharides (asterisk). Enzyme activities determined were: xylanase (filled square), arabinofuranosidase (open triangle), endoglucanase (closed circle), β-glucosidase (open circle) and β-xylanase (filled circle).Standard deviation of triplicate assays less than 10%
Cellobiose was totally consumed up to 90 h, although soon after 20 h of incubation a regular level of glucose was released. A peak of xylanase coincident with that of the endoglucanase appeared at approximately 45 h of fungal growth (Fig. 2b). Cellobiose induced endoglucanase activity superior to xylanase, confirming the inductive effect of cellobiose on the production of cellulolytic enzymes by T. aurantiacus.
Xylanase produced in the medium supplied with hydrolyzed xylan from sugarcane was very low (Fig. 2c), similar to the levels produced by washed-mycelia, despite the use a relatively high substrate concentration (20 mM). According to the literature, the enzyme production is proportional to the amount of the inducer within a range. At high inducer concentrations this correlation is lost (Biely et al. 1980).
Xylanase was induced by HXSB after a short lag period and two peaks of enzyme production were detected at 12 and 66 h, go along with slow time-consuming of xylobiose. The second peak was coincident with the reduction in the xylose content (Fig. 2c). The induction time in xylan was extended for 50 h; however, the synthesis of the enzyme continued for a long period.
Conclusions
Thermoascus aurantiacus secreted most of the hemicellulolytic and cellulolytic enzymes when cultivated in xylans which acted as potent inducers for the production of xylanases.
Other stimulators were xylooligosaccharides which were in fact more effective stimulators of endoxylanase production than xylose. Almost all xylobiose remained in the medium after fungal growth as a consequence of low β-xylosidase activity produced by T. aurantiacus. Therefore, xylobiose must be the natural inducer of endoxylanase. Regardless of the inoculation mode, spores or washed-mycelia, the production of xylanase was always higher when xylose or xylobiose were added separately. Xylose does not repress enzyme induction in T. aurantiacus when used in low quantities.
Low activities of cellulases are produced by this fungus regardless of inducer. Despite excellent growth on easily metabolisable carbohydrates (e.g. xylose, xylobiose, cellobiose and HXSB), only constitutive levels of cellulases were produced. Cellulase activity was always determined in the presence of xylanase activity, suggesting that both induced activities are linked.
References
Alam M, Gomes I, Mohiuddin G, Hoq MM (1994) Production and characterization of thermostable xylanases by Thermoascus lanuginosus and Thermoascus aurantiacus grown on lignocelluloses. Enzym Microb Technol 16:298–302
Aro N, Pakula T, Penttila M (2005) Transcriptional regulation of plant cell wall degradation by filamentous fungi. FEMS Microbiol Rev 29:719–739
Auer CG, Krugner TL, Barrichelo LEG (1988) Fungos termófilos em pilhas decavacos de Eucalyptus spp. com auto-aquecimento. IPEF, Piracicaba, 38:28–32
Bedford MR, Classen HL (1992) The influence of dietary xylanase on intestinal viscosity and molecular weight distribution of carbohydrates in rye-fed broiler chick. In: Visser J, Beldman G, Vansomenen AK, Voragen AGJ (eds) Xylans and Xylanases. Elsevier, Amsterdam, pp 361–370
Biely P, Kratky Z, Vrsanska M, Urmanicova D (1980) Induction and Inducers of Endo- 1, 4-P-xylanase in the Yeast Cryptococcus albidus Eur. J Biochem 108:323–329
Brienzo M, Arantes V, Milagres AMF (2009a) Enzymology of the thermophilic ascomycetous fungus Thermoascus aurantiacus. Fungal Biol Rev 22:120–130
Brienzo M, Siqueira AF, Milagres AMF (2009b) Search for optimum conditions of sugarcane bagasse hemicellulose extraction. Biochem Eng J 46:199–204
Chang VS, Holtzapple MT (2000) Fundamental factors affecting biomass enzymatic reactivity. Appl Biochem Biotechnol 84–86:5–37
Chavez R, Bull P (2006) Eyzaguirre J (2006) The xylanolytic enzyme system from the genus Penicillium—Review. J Biotechnol 123:413–433
Couri S, Terzi SC, Pinto GAS, Freitas SP, Da Costa ACA (2000) Hydrolytic enzyme production in solid-state fermentation by Aspergillus niger 3T5B8. Process Biochem 36:255–261
Da Silva R, Lago EL, Merheb CW, Macchione MM, Park YK, Gomes E (2005) Production of xylanase and CMCase on solid state fermentation in different residues by Thermoascus aurantiacus. Braz J Microbiol 36:235–241
Dobrev GT, Pishtiyski IG, Stanchev VS, Mircheva R (2007) Optimization of nutrient medium containing agricultural wastes for xylanase production by Aspergillus niger B03 using optimal composite experimental design. Bioresource Technol 98:2671–2678
Fadel M, Fouda MS (1993) Physiological studies on xylanase production by Penicillium funiculosum on some agricultural wastes. Zentralbl Mikrobiol 148:304–312
Gabrielii I, Gatenholm P, Glasser WG, Jain RK, Kenne L (2000) Separation, characterization and hydrogel-formation of hemicellulose from aspen wood. Carbohydr Polym 43:367–374
Gomes DJ, Gomes J, Steiner W (1994) Factors influencing the induction of endo-xylanase by Thermoascus aurantiacus. J Biotechnol 33:87–94
Gomes I, Gomes J, Gomes DJ, Steiner W (2000) Simultaneous production of high activities of thermostable endoglucanase and β-glucosidase by the wild thermophilic fungus Thermoascus aurantiacus. Appl Microbiol Biot 53:461–468
Juhász T, Szengyel Z, Reczey K, Siika-Aho M, Viikari L (2005) Characterization of cellulases and hemicellulases produced by Trichoderma reesei on various carbon sources. Process Biochem 40:3519–3525
Kalogeris E, Christakopoulos P, Kekos D, Macris BJ (1998) Studies on the solid-state production of thermostable endoxylanases from Thermoascus aurantiacus: Characterization of two isozymes. J Biotechnol 60:155–163
Kalogeris E, Christakopoulos P, Vrsanská M, Kekos D, Biely P (2001) Catalytic properties of the endoxylanase I from Thermoascus aurantiacus. J Mol Catal B:Enzym 11:491–501
Kang SW, Park YS, Lee JS, Hong SI, Kim SW (2004) Production of cellulases and hemicellulases by Aspergillus niger KK2 from lignocellulosic biomass. Bioresource Technol 91:153–156
Khandke KM, Vithayathil PJ, Murthy SK (1989) Purification of xylanase, β-glucosidase, endocellulase, and exocellulase from a thermophilic fungus, Thermoascus aurantiacus. Arch Biochem Biophys 274:491–500
Kovács K, Szakacs G, Zacchi G (2009) Comparative enzymatic hydrolysis of pretreated spruce by supernatants. Bioresource Technol 100:1350–1357
Kuhad RC, Singh A (1993) Lignocellulosic biotechnology: current and future prospects. Crit Rev Biotechnol 13:151–172
Leite RSR, Alves-Prado HF, Cabral H, Pagnocca FC, Gomes E, Da-Silva R (2008) Production and characteristics comparison of crude β-glucosidases produced by microorganisms Thermoascus aurantiacus e Aureobasidium pullulans in agricultural wastes. Enzyme Microb Technol 43:391–395
Lima DU, Oliveira RC, Buckeridge MS (2003) Seed storage hemicelluloses as wet- end additives in papermaking. Carbohydr Polym 52:367–373
Maat J, Roza M, Verbakel J, Stam H, daSilra MJS, Egmond MR, Hagemans MLD, van Garcom RFM, Hessing JGM, van Derhondel CAMJJ, van Rotterdam C (1992) Xylanases and their application in bakery. In: Visser J, Beldman G, vanSomeren MAK, Voragen AGJ (eds) Xylans and xylanases. Elsevier, Amsterdam, pp 349–360
Mansfield SD, Mooney C, Saddler JN (1999) Substrate and enzyme characteristics that limit cellulose hydrolysis. Biotechnol Prog 15:804–816
Maslen SL, Goubet F, Adam A, Dupree P, Stephens E (2007) Structure elucidation of arabinoxylan isomers by normal phase HPLC-MALDI-TOF/TOF-MS/MS. Carbohyd Res 342:724–735
Matsuo M, Endou A, Okada T, Yamaoka Y (1998) Purification and characterization of β-xylosidase from Thermoascus sp. J Fermentation Bioeng 86:403–405
Milagres AMF, Santos E, Piovan T, Roberto IC (2004) Production of xylanase by Thermoascus aurantiacus from sugar cane bagasse in an aerated growth fermentor. Process Biochem 39:1387–1391
Miller GL (1959) Use of dinitrosalicylic acid reagent for determination of reducing sugar. Anal Chem 31:426–428
Parry NJ, Beever DE, Owen E, Nerinckx W, Claaeyssens M, Beeumen JV (2002) Biochemical characterization and mode of action of a thermostable endoglucanase purified from Thermoascus aurantiacus. Arch Biochem Biophys 404:243–253
Puchart V, Katapodis P, Biely P, Kremnicky L, Christakopoulos P, Vrsanska M, Kekos D, Marcis BJ, Bhat MK (1999) Production of xylanases, mannanases, and pectinases by the thermophilic fungus Thermomyces lanuginosus. Enzym Microb Technol 24:355–361
Purkarthofer H, Steiner W (1995) Induction of endo-β-xylanase in the fungus Thermomyces lanuginosus. Enzym Microb Technol 17:114–118
Rao M, Gaikwad S, Mishra C, Deshpande V (1988) Induction and catablolite repression of cellulase in Penicillium funiculosum. Appl Biochem Biotechnol 19:129–137
Roche N, Desgranges C, Durand A (1994) Study on the solid-state production of a thermostable alpha β-L-arabinofuranosidase of Thermoascus aurantiacus on sugar beet pulp. J Biotechnol 38:43–50
Sonnleitner B, Fiechter A (1983) Advantages of using thermophiles in biotechnological processes: expectations and reality. Trends Biotechnol 3:74–80
Tan L, Mayers P, Saddler J (1987) Purification and characterization of a thermostable xylanase from a thermophilic fungus Thermoascus aurantiacus. Can J Microbiol 33:389–992
Tanaka M, Taniguchi MA, Matsumo R, Kamikubo T (1981) Purification and properties of cellulases from Eupenicillium javanicum. J Ferment Technol 59:177–183 that limit cellulose hydrolysis. Biotechnol Prog 15:804–816
Vardakou M, Katapodis P, Samiotaki M, Kekos D, Panayotou G, Christakopoulos P (2003) Mode of action of family 10 and 11 endoxylanases on water-unextractable arabinoxylan. Int J Biol Macromol 33:129–134
Vogel HJ (1956) A convenient growth medium for Neuspora crassa (medium N). Microbial Genetic Bulletin 13:42–43
Acknowledgments
The authors are grateful to Fundação de Amparo a Pesquisa do Estado de São Paulo (FAPESP—grants 06/03564-9) and Conselho Nacional Desenvolvimento Cientifico e Tecnologico (CNPq) for financial support.
Author information
Authors and Affiliations
Corresponding author
Rights and permissions
About this article
Cite this article
Brienzo, M., Monte, J.R. & Milagres, A.M.F. Induction of cellulase and hemicellulase activities of Thermoascus aurantiacus by xylan hydrolyzed products. World J Microbiol Biotechnol 28, 113–119 (2012). https://doi.org/10.1007/s11274-011-0798-z
Received:
Accepted:
Published:
Issue Date:
DOI: https://doi.org/10.1007/s11274-011-0798-z